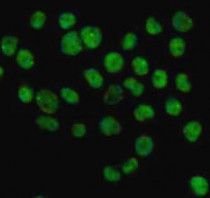

ARG58885
anti-hnRNP L antibody
anti-hnRNP L antibody for ICC/IF,IHC-Formalin-fixed paraffin-embedded sections,Western blot and Human,Mouse,Rat
概述
| 产品描述 | Rabbit Polyclonal antibody recognizes hnRNP L |
|---|---|
| 反应物种 | Hu, Ms, Rat |
| 应用 | ICC/IF, IHC-P, WB |
| 宿主 | Rabbit |
| 克隆 | Polyclonal |
| 同位型 | IgG |
| 靶点名称 | hnRNP L |
| 抗原物种 | Human |
| 抗原 | Recombinant fusion protein corresponding to aa. 282-589 of Human hnRNP L (NP_001524.2). |
| 偶联标记 | Un-conjugated |
| 別名 | hnRNP L; HNRPL; hnRNP-L; P/OKcl.14; Heterogeneous nuclear ribonucleoprotein L |
应用说明
| 应用建议 |
|
||||||||
|---|---|---|---|---|---|---|---|---|---|
| 应用说明 | * The dilutions indicate recommended starting dilutions and the optimal dilutions or concentrations should be determined by the scientist. | ||||||||
| 阳性对照 | HT-29 | ||||||||
| 实际分子量 | 64 kDa |
属性
| 形式 | Liquid |
|---|---|
| 纯化 | Affinity purified. |
| 缓冲液 | PBS (pH 7.3), 0.02% Sodium azide and 50% Glycerol. |
| 抗菌剂 | 0.02% Sodium azide |
| 稳定剂 | 50% Glycerol |
| 存放说明 | For continuous use, store undiluted antibody at 2-8°C for up to a week. For long-term storage, aliquot and store at -20°C. Storage in frost free freezers is not recommended. Avoid repeated freeze/thaw cycles. Suggest spin the vial prior to opening. The antibody solution should be gently mixed before use. |
| 注意事项 | For laboratory research only, not for drug, diagnostic or other use. |
生物信息
| 数据库连接 |
Swiss-port # P14866 Human Heterogeneous nuclear ribonucleoprotein L Swiss-port # Q8R081 Mouse Heterogeneous nuclear ribonucleoprotein L |
|---|---|
| 基因名称 | HNRNPL |
| 全名 | heterogeneous nuclear ribonucleoprotein L |
| 背景介绍 | Heterogeneous nuclear RNAs (hnRNAs) which include mRNA precursors and mature mRNAs are associated with specific proteins to form heterogenous ribonucleoprotein (hnRNP) complexes. Heterogeneous nuclear ribonucleoprotein L is among the proteins that are stably associated with hnRNP complexes and along with other hnRNP proteins is likely to play a major role in the formation, packaging, processing, and function of mRNA. Heterogeneous nuclear ribonucleoprotein L is present in the nucleoplasm as part of the HNRP complex. HNRP proteins have also been identified outside of the nucleoplasm. Exchange of hnRNP for mRNA-binding proteins accompanies transport of mRNA from the nucleus to the cytoplasm. Since HNRP proteins have been shown to shuttle between the nucleus and the cytoplasm, it is possible that they also have cytoplasmic functions. Two transcript variants encoding different isoforms have been found for this gene. [provided by RefSeq, Jul 2008] |
| 生物功能 | Splicing factor binding to exonic or intronic sites and acting as either an activator or repressor of exon inclusion. Exhibits a binding preference for CA-rich elements. Component of the heterogeneous nuclear ribonucleoprotein (hnRNP) complexes and associated with most nascent transcripts. Associates, together with APEX1, to the negative calcium responsive element (nCaRE) B2 of the APEX2 promoter. [UniProt] |
| 细胞定位 | Cytoplasm, Nucleus, nucleoplasm. [UniProt] |
| 预测分子量 | 64 kDa |
| 翻译后修饰 | Several isoelectric forms of the L protein are probably the results of post-translational modifications. Phosphorylation at Ser-544 by CaMK4 enhances interaction with a CaMK4-responsive RNA element (CaRRE1), and prevents inclusion of the stress axis-regulated exon (STREX) of the KCNMA1 potassium channel transcripts upon membrane depolarization. [UniProt] |
检测图片 (2) Click the Picture to Zoom In